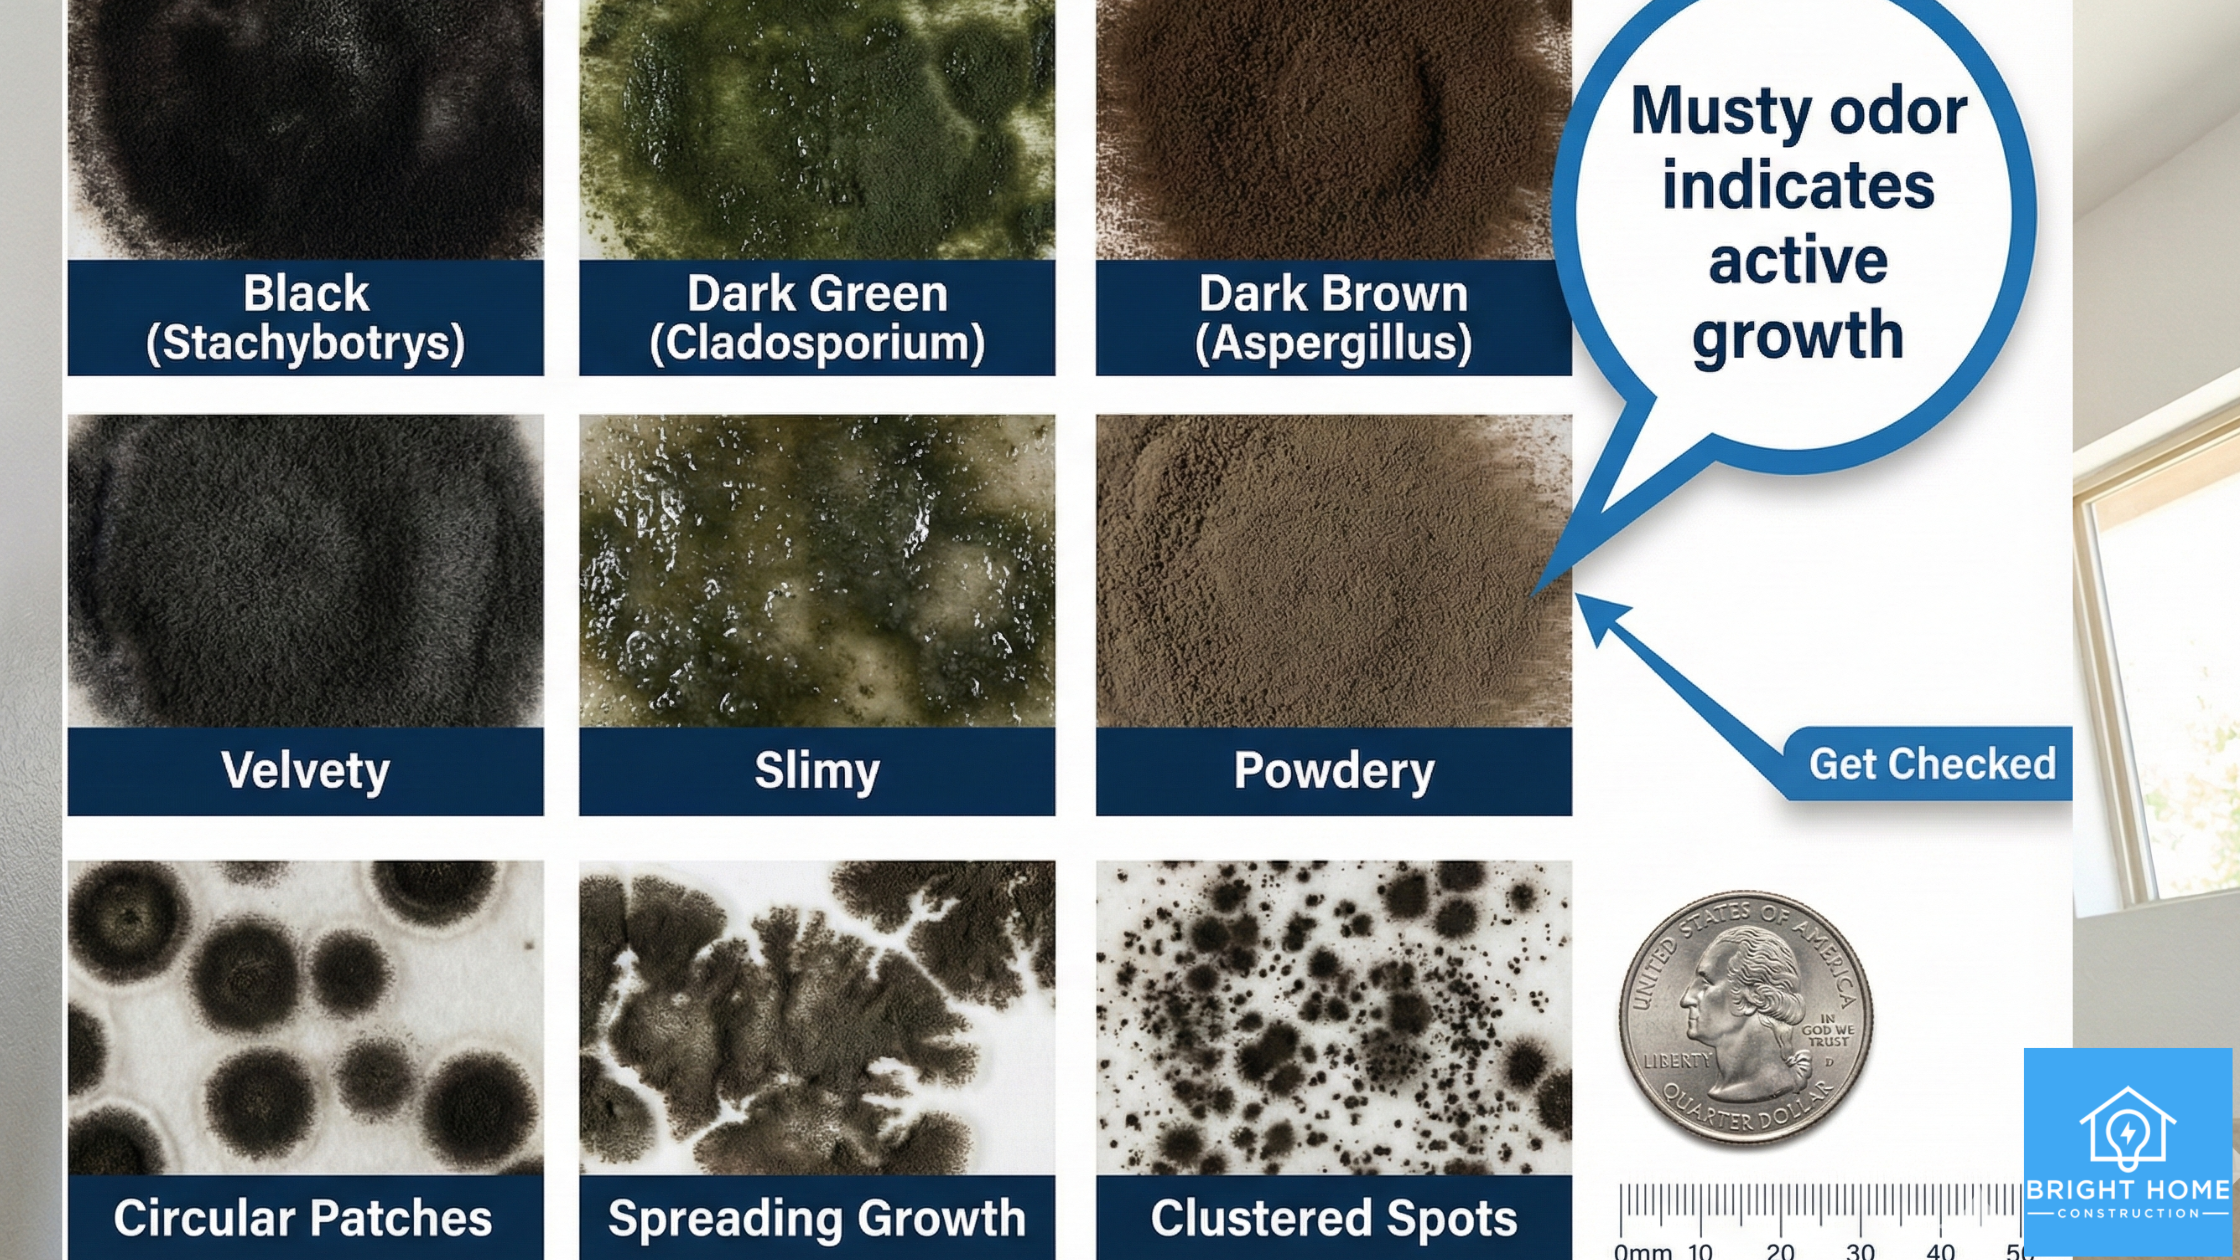
A chart displays different types of mold by color, texture, and pattern, with a message indicating that a musty odor signals active growth and a reminder to get checked.

What Is Black Mold and Should You Be Worried?
Fear vs. Facts
The internet has made black mold sound terrifying. You’ve probably seen headlines screaming about “toxic black mold” causing serious health problems, lawsuits, and home disasters. So when you spot a dark patch on your bathroom ceiling or behind a leaky pipe, it’s natural to panic.
Here’s the truth: Not every dark mold spot is dangerous black mold. But not every dark spot should be ignored either.
The reality is somewhere in the middle—and understanding that middle ground is what keeps you safe without losing sleep.
In this guide, we’ll answer the questions keeping you up at night: What exactly is black mold? Is it actually as dangerous as people say? How do you know if you should worry? And most importantly, what should you do if you find it?
By the end, you’ll understand the real facts about black mold—and you’ll know exactly when to call for professional help.

What Is Black Mold? The Science (Simplified)
Black mold typically refers to Stachybotrys chartarum, a dark greenish-black mold that grows in damp environments.
But here’s something important: the term “black mold” isn’t actually scientific. There are dozens of mold species that are black or dark-colored. Some are harmless. Some are more problematic. The one that gets all the scary headlines is Stachybotrys chartarum—but you don’t actually need a microscope to know how to treat any mold you find.
What Does Black Mold Need to Grow?
Black mold, like all molds, is a fungus that grows from spores. It needs two things to thrive:
-
Moisture — Consistently damp environments (humidity above 50%, or water damage)
-
Organic material — Something to eat, like wood, drywall, insulation, or dust
When these two things come together in your home—say, a roof leak hitting drywall, or a bathroom with poor ventilation—mold can start growing within 24–48 hours.
Where Black Mold Commonly Appears
Black mold typically grows in:
-
Drywall (after water damage, flooding, or chronic moisture)
-
Behind walls (from hidden pipe leaks or moisture intrusion)
-
Under flooring (subfloor water damage, condensation)
-
Bathrooms (especially around tubs, showers, exhaust fan areas)
-
Basements and crawl spaces (groundwater or poor drainage)
-
HVAC systems and ductwork (condensation buildup or clogged drain lines)
-
Windows and windowsills (condensation from temperature changes)
-
Air conditioning units (condensation backup)
The key pattern? Mold appears wherever moisture is present long enough for it to establish.
What Does Black Mold Look Like?
If you’re trying to identify black mold in your home, here’s what to look for:
Visual Characteristics
Color: Dark green, black, or charcoal-colored patches. It’s usually darker than other mold species.
Texture: Can appear fuzzy, slimy, wet, or powdery depending on the stage of growth and moisture level.
Pattern: Often appears in clusters or patches rather than as a thin film. It may look spotty and concentrated.
Size: Can range from small spots (less than an inch) to large colonies covering several feet.
Smell
Black mold produces a distinctive musty, earthy odor—often stronger than other mold types. If you smell it, mold is actively growing nearby, whether you can see it or not.
Important Clarification: Not All Dark Mold Is “Black Mold”
Here’s where the confusion starts: many dark-colored molds exist, and not all are Stachybotrys chartarum. Some are completely harmless. Some are more problematic.
The good news? You don’t need to identify the exact species to know what to do about it. If you see dark mold growing in your home—especially in areas with moisture—it should be inspected and addressed. Period.
The type of mold matters less than the fact that mold means moisture is present, and moisture causes problems.
Is Black Mold Dangerous? The Honest Answer
This is where we separate fact from fiction.
The short answer: Black mold can pose health risks, especially for vulnerable populations. It can also cause property damage. But it’s not an automatic death sentence, and it’s not as catastrophically toxic as some online sources claim.
The honest answer: It depends.
Health Risks: Who’s Actually at Risk?
Black mold produces spores and compounds that can irritate respiratory systems and trigger allergic reactions—but the severity varies significantly based on:
Exposure level — How much mold is present and how long you’re exposed
Individual sensitivity — Some people are highly sensitive; others barely notice
Age and health — Young children, the elderly, and immunocompromised individuals are more vulnerable
Pre-existing conditions — People with asthma, allergies, or lung disease face a higher risk
Reported Symptoms (When Exposure Occurs)
People exposed to black mold may experience:
-
Coughing or persistent cough
-
Sneezing and nasal congestion
-
Red or itchy eyes
-
Skin irritation or rashes
-
Headaches
-
Throat irritation
-
Wheezing or shortness of breath (especially in asthma sufferers)
Important note: These symptoms are also caused by dozens of other things (allergies, colds, seasonal changes, poor air quality). Just because you have a cough doesn’t mean black mold is the cause.
Vulnerable Populations: When to Take Extra Caution
Certain groups should be more cautious around mold:
-
Children — Developing immune systems and spend more time on floors where mold spores settle
-
Elderly — Often have weaker immune systems
-
Pregnant women — Want to minimize exposure to potential irritants
-
People with asthma — Mold spores trigger attacks and complications
-
Immunocompromised individuals — Transplant recipients, HIV+ individuals, cancer patients undergoing treatment
-
People with chronic respiratory disease — COPD, emphysema, etc.
If you fall into one of these categories and you discover mold, professional removal becomes even more important.
Property Risks: The Real Damage
Honestly, the property damage from black mold might be more concerning than the health risks for most homeowners.
Here’s why:
Spreads quickly: If the moisture source remains, mold spreads aggressively through drywall, wood, insulation, and other materials.
Structural damage: Mold breaks down the materials it grows on. Over time, it weakens wood framing, compromises drywall integrity, and can eventually damage the structural elements of your home.
Hidden damage: Mold behind walls continues growing undetected, causing extensive damage before you even know it’s there.
Expensive remediation: Once mold spreads extensively, professional removal becomes a major undertaking—and an expensive one.
Reduces home value: Disclosed mold history can significantly impact home value and insurability.
Signals bigger problems: Mold almost always indicates water damage or moisture intrusion. The mold itself is the symptom; the water problem is the disease.
When Should You Be Worried? The Real Decision Tree
Not every dark spot requires immediate panic. But some situations absolutely demand attention. Here’s how to know the difference:
You Should Be Concerned If:
Mold appeared after water damage or flooding — This indicates active moisture and ongoing conditions that support mold growth
You have visible mold and the musty odor is strong — This suggests active, established mold growth
Mold keeps returning in the same spot — The moisture source was never addressed; it’ll keep coming back
The mold patch is larger than a few square feet — Significant growth usually means it’s been there for weeks or longer
You’re finding mold inside walls, in HVAC systems, or in ceilings — This indicates systemic moisture problems
Anyone in your home has unexplained respiratory symptoms that improve when you leave the house — Mold could be a contributing factor
You discover mold after a pipe leak, roof damage, or flooding — Professional assessment is needed to check for hidden spread
You Can Likely Handle Smaller Issues Yourself (If):
It’s a small spot (less than 1-2 square feet) in a low-risk area — Consider professional assessment first; preventive treatment is safer
It’s clearly just surface mold with no musty odor — Could be surface issue, but verify moisture source is handled
Even in these cases, we recommend professional assessment. Determining what’s safe to handle yourself requires expertise, and the cost of a $200 inspection is cheap compared to the cost of missing a bigger problem.
What NOT to Do (Common Mistakes)

Before we talk about what to do, let’s cover what NOT to do:
Don’t Aggressively Scrub or Brush the Mold
Scrubbing disturbs mold colonies and releases spores into the air, spreading the problem and exposing you to more spores. This can make the situation worse.
Don’t Paint or Caulk Over It
Paint doesn’t kill mold—it just hides it. The mold continues growing underneath, spreading invisibly. Eventually, it’ll return more aggressively.
Don’t Use Bleach as Your Only Solution
While bleach can kill surface mold, it doesn’t address the moisture source. Mold will return. Plus, bleach doesn’t penetrate porous materials like drywall—it only kills surface spores.
Don’t Ignore the Moisture Source
Even if you kill visible mold, if the moisture continues, mold will return. You must address the underlying water problem.
Don’t Assume It’s “Just Mold” and Not a Health Concern
Take it seriously. If you have vulnerable populations in your home, professional assessment is wise.
Don’t Try to Remediate Large Infestations Yourself
Large mold colonies require professional equipment, containment procedures, and expertise. DIY attempts often spread spores throughout your home.
When to Call a Professional
You should call for professional mold inspection and removal when:
Mold is Larger Than a Few Square Feet
Professional equipment and containment procedures prevent spore spread and ensure complete removal.
Mold is in Hidden Areas
Behind walls, in attics, crawl spaces, or HVAC systems. You can’t properly assess hidden mold without professional equipment like thermal imaging and moisture meters.
You Can’t Find or Fix the Moisture Source
Professional inspectors can identify hidden water issues and recommend solutions.
The Mold Keeps Returning
Recurring mold means the moisture problem wasn’t fully solved. Professionals can investigate why and develop a complete solution.
You Have Vulnerable People at Home
Children, the elderly, immunocompromised individuals, or anyone with respiratory conditions benefit from professional assessment and removal.
It Appeared After Water Damage or Flooding
Professional assessment ensures you’re not missing hidden mold in walls, under flooring, or in other concealed areas.
You’re Selling or Buying the Home
Professional inspection and documentation protect all parties and ensure proper remediation before sale.
What Professionals Do (And Why It Matters)
When you call for professional mold removal, here’s what a competent company does:
1. Complete Inspection
-
Visual assessment of visible mold
-
Moisture detection with specialized equipment
-
Identification of water sources and problem areas
-
Assessment of hidden moisture in walls, attics, crawl spaces
2. Testing and Documentation
-
Sometimes includes mold sampling (if needed for insurance or property transaction)
-
Documentation of findings for insurance claims
-
Clear explanation of what they found and why
3. Moisture Source Identification
-
Finding the root cause (leak, poor ventilation, condensation issue, etc.)
-
Explaining what’s causing the problem
-
Recommending fixes to prevent recurrence
4. Proper Mold Removal
-
Containment procedures (negative pressure, barriers)
-
HEPA filtration to prevent spore spread
-
Complete removal of affected materials if necessary
-
Treatment to prevent recurrence
5. Moisture Solution
-
Fixing underlying water problems
-
Improving ventilation
-
Drainage correction
-
Material replacement if needed
6. Documentation
-
Before and after photos
-
Written report for insurance
-
Recommendations for follow-up
The key difference between professional and DIY: Professionals ensure the moisture source is fixed, preventing the mold from coming back. That’s worth every penny.
The Real Black Mold Question: Should You Be Worried?
Let’s bring this back to what you actually care about: Should you be worried if you find black mold?
The answer is: Be appropriately concerned, not panicked.
Here’s the mindset shift that helps:
Instead of: “Black mold is toxic and will destroy my home and kill my family.”
Think: “Mold indicates moisture problems. Moisture causes damage. I need to address this intelligently and promptly.”
That’s the perspective that leads to good decisions.
Mold is a sign that something is wrong—usually water infiltration or excess moisture. Addressing that something solves the mold problem and prevents much bigger damage down the road.
You should be worried about:
-
The moisture problem causing the mold
-
Hidden mold behind walls spreading unseen
-
Structural damage from unchecked mold
-
Health impacts if vulnerable people are in the home
-
Home value and insurability
You don’t need to worry about:
-
Instant catastrophic health consequences
-
Rare toxic varieties (they’re less common than the internet suggests)
-
Any mold you catch early and address properly
A Message from Bright Home: Here’s What We See Every Week
We inspect homes for mold every single week in the Phoenix area. Here’s what we’ve learned:
Most homeowners who find mold are more worried than they need to be. They’ve read scary articles. They’ve heard horror stories. They’re afraid it’s a disaster.
And then they call us, and we inspect it, and they feel immediate relief because they now have clarity instead of anxiety.
We’ve also seen cases where homeowners weren’t worried enough—they ignored a small spot, thinking it wasn’t a big deal. Six months later, the mold had spread behind walls, and what could have been a $2,000 remediation became a $15,000 project.
The key isn’t fear—it’s informed action.
The best thing you can do if you find black mold? Don’t panic. But also don’t ignore it. Call for a professional assessment.
We’ll tell you honestly what you’re dealing with. We’ll explain your options. And we’ll help you fix it the right way so it doesn’t come back.
Most importantly, you’ll sleep better knowing what you’re dealing with.
What To Do If You Found Black Mold: Your Action Plan
Step 1: Document It
-
Take photos from multiple angles
-
Note the location, size, and whether it’s growing
-
Write down when you first noticed it
-
Note any musty smells or moisture you’ve observed
Step 2: Don’t Touch It (Yet)
-
Don’t scrub, wipe, or spray it
-
Don’t paint over it
-
Don’t turn on fans that might spread spores
-
Just leave it alone until you get professional guidance
Step 3: Address the Obvious Moisture Source (If Possible)
-
Is there a visible leak? Stop the water if you safely can
-
Is it in a bathroom with no ventilation? Start running the exhaust fan
-
Is it near a window? Improve ventilation
-
Is there standing water? Remove it safely
Step 4: Call for a Free Professional Assessment
Don’t wait. Mold spreads over time, and the longer it sits, the more it grows.
Call Bright Home Construction & Restoration at (480) 674-8111 for a free black mold inspection. Our certified inspectors will:
-
Thoroughly assess the mold
-
Identify the moisture source
-
Explain exactly what you’re dealing with (no scary jargon)
-
Provide honest recommendations
-
Help you understand your options and costs
-
Coordinate with your insurance if applicable
We respond within 30 minutes in the East and West Valley. Available 24/7, including holidays.
Step 5: Take Action
-
Schedule professional removal if needed
-
Fix the underlying moisture problem
-
Follow professional recommendations to prevent recurrence
-
Keep the area well-ventilated until addressed
FAQ: Black Mold Questions Answered
How quickly does black mold grow?
Black mold can begin growing within 24–48 hours of continuous moisture exposure. Visible colonies take longer to develop—usually 1–3 weeks depending on conditions.
Can I test my mold to see if it’s the “toxic” kind?
You can get mold samples tested, but honestly, it doesn’t change what you should do. Any mold growing in your home indicates moisture and should be addressed. The species matters less than the fact that it’s there. Unless you’re in a specific situation (real estate transaction, insurance claim), professional assessment without lab testing is usually sufficient.
Is black mold covered by homeowner’s insurance?
It depends on the cause. If mold resulted from sudden water damage (burst pipe, flood), it’s typically covered. If it resulted from gradual moisture (poor ventilation, slow leak), it may not be covered. Check your policy and call your insurer. We can help with documentation if needed.
Can I catch serious illnesses from black mold?
Serious illnesses from mold exposure are rare, especially in short-term exposure. However, prolonged exposure in vulnerable people can contribute to respiratory problems. If anyone in your home has unexplained health issues, see a doctor and get the mold assessed.
Why does black mold keep coming back?
Mold returns when the moisture source isn’t fixed. If you clean the mold but don’t address the leak, condensation issue, or ventilation problem, mold will grow back. Professional remediation includes fixing the moisture source.
Can bleach kill black mold permanently?
Bleach kills surface mold spores but doesn’t penetrate porous materials or address the moisture source. Mold returns. Professional remediation uses multiple approaches and fixes the underlying moisture problem.
Should I move out if I find black mold?
For small, contained mold infestations, moving out isn’t necessary. For extensive mold, especially if anyone is experiencing health symptoms, temporary relocation during professional remediation may be wise. Professional advice is case-specific.
How much does black mold removal cost?
It varies greatly depending on the extent and location. Small, contained mold might cost $500–$2,000. Extensive infestations can cost $5,000–$30,000+. The good news: catching it early dramatically reduces costs. Get a professional assessment for an accurate estimate.
Black Mold: The Bottom Line
Black mold is real. It should be taken seriously. But it’s not the apocalyptic threat that internet headlines suggest.
Here’s what you need to know:
-
Black mold grows in damp environments and indicates moisture problems
-
It poses health risks primarily to vulnerable populations with prolonged exposure
-
It causes more property damage than health damage in most cases
-
Most homeowners worry more than necessary once they understand what they’re dealing with
-
Professional assessment removes anxiety and provides clear direction
-
Catching it early prevents expensive damage and complicated remediation
-
Fixing the moisture source prevents recurrence
And here’s what to do:
If you found mold—don’t panic, but also don’t ignore it. Call for a professional assessment. A simple inspection costs far less than the damage mold causes if you wait.
You don’t have to diagnose this yourself. That’s what we’re here for.
Ready to Stop Worrying?
Schedule Your Free Black Mold Inspection
If you’ve found mold and you’re worried, get clarity. Call Bright Home Construction & Restoration at (480) 674-8111 for a free, professional assessment. Our inspectors will explain exactly what you’re dealing with and what needs to happen next.
Available 24/7. We respond within 30 minutes in the Valley.
Bonus: Download “Black Mold Warning Signs & What to Do Next”
Get our free guide covering:
-
How to spot black mold
-
When to worry and when to stay calm
-
Step-by-step action plan
-
Questions to ask a professional
-
Insurance documentation tips
Why Phoenix Homeowners Trust Bright Home for Mold Concerns
We serve Phoenix families who’ve discovered mold and felt panic. We’ve learned that what most people need is clarity and calm expertise—not scary diagnoses.
We inspect thoroughly. We explain honestly. We fix the problem the right way. And we prevent it from coming back.
Because your peace of mind matters more than creating fear.
Bright Home Construction & Restoration
Serving Phoenix, Tempe, Mesa, Scottsdale, Gilbert, Glendale, Chandler, Peoria, and Surprise
(480) 674-8111 — Available 24/7
www.brighthomeconstruction.com
4675 E Cotton Center Blvd Ste 171, Phoenix, AZ 85040
Licensed – Bonded – Insured – Accredited
